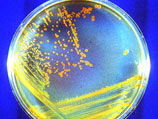

|
 |
 |
 |
| ||||||||||||
 |
Вокруг света
Ученые нашли "источник жизни на Земле" - бактерий, способных выдержать вакуум
1:18PM Monday, Jul 19, 2010
Учеными обнаружен простейший микроб, который объявлен ими источником биологической жизни на Земле и Вселенной в целом. Научный коллектив из бразильского Рио-де-Жанейро провел серию экспериментов с бактерией деинококкус радиодаранс (Deinococcus radiodurans), по результатам которой сделал вывод, что эти организмы являются "семенами биологической жизни", передает ИТАР-ТАСС. Как оказалось, эти бактерии обладают практически неограниченной способностью к выживанию. В ходе проведенных экспериментов они выдерживали смертельные для всех других известных биологических организмов дозы радиации, агрессивные химические среды, предельные температуры как холода, так и тепла, длительное нахождение в вакууме. "Высочайшая степень выживаемости деинококкуса делает ее главным кандидатом на источник биологической жизни на космических просторах", - заявил руководитель исследований профессор Айван Полино-Лима. Эти свойства бактерии обнаружены им пять лет назад во время работ по обработке пищевых упаковок радиацией. Предельная биологическая устойчивость этой бактерии объясняется тем фактом, что она способна иметь до 10 полных копий своего генофонда. Обычно, организмы ограничиваются одной. В ходе экспериментов ученые моделировали пребывание в космосе, помещая бактерию в сильный радиационный фон, в вакуум и подвергая заморозке, уточняет NewKerala.com. Ведь именно в таких условиях находятся метеориты. В этой обстановке бактерии не только выживали, но и, возвращаясь в нормальную среду, принимались размножаться. Исследователи считают, что такие микроорганизмы могли переносить жизнь между планетами на стадии формирования солнечной системы. Впервые сферическая бактерия красного цвета была обнаружена около полувека назад, когда банка отварной солонины стала гнить несмотря на то, что была стерилизована радиацией.
По материалам NewsRu.com
Другие новости по теме
• ОБСЕ направит в Киргизию группу полицейских советников…• Таиландский суд повторно отпустил Плетнева под залог… • Пакистанский истребитель дебютировал на Фарнборо… • Британский премьер решил вступиться за BP перед Обамой… • Иран обошел санкции ООН с помощью банка в Германии… • В Австралии украли двухсоткилограммовый бронзовый фонтан… • В США начались испытания робота-оруженосца… • Росбанк получит бизнес-центр "Домников"… • Канада подтвердила намерение купить 65 истребителей F-35… • Плетнев предстал в Таиланде перед судом… • Четверых французских подростков арестовали за стрельбу в полицейских… • Гондурас обзавелся копией Эйфелевой башни… • На мексиканской вечеринке убили 17 человек… • В Пуэрто-Рико арестован однин из самых разыскиваемых боссов наркомафии… • В шахте на северо-западе Китая погибли 28 человек… • Подросток в наручниках сбежал из полицейской машины…
|
| News Central Home | News Central Resources | Portal News Resources | Help | Login |